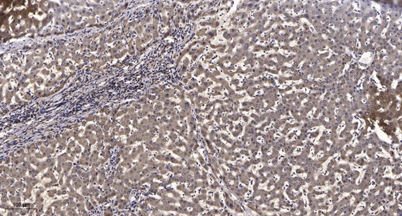

Overview
-
 Western Blot analysis of various cells using IRAK-2 Polyclonal Antibody diluted at 1:2000
Western Blot analysis of various cells using IRAK-2 Polyclonal Antibody diluted at 1:2000 -
 Western Blot analysis of 293 cells using IRAK-2 Polyclonal Antibody diluted at 1:2000
Western Blot analysis of 293 cells using IRAK-2 Polyclonal Antibody diluted at 1:2000 -
Immunohistochemical analysis of paraffin-embedded human liver cancer. 1, Antibody was diluted at 1:200(4° overnight). 2, Tris-EDTA,pH9.0 was used for antigen retrieval. 3,Secondary antibody was diluted at 1:200(room temperature, 45min).
Immunohistochemical analysis of paraffin-embedded human liver cancer. 1, Antibody was diluted at 1:200(4° overnight). 2, Tris-EDTA,pH9.0 was used for antigen retrieval. 3,Secondary antibody was diluted at 1:200(room temperature, 45min).
关闭
在线咨询
Online consultation
-
在线咨询
-
技术支持

关注微信公众号



 下载说明 ①
下载说明 ①





